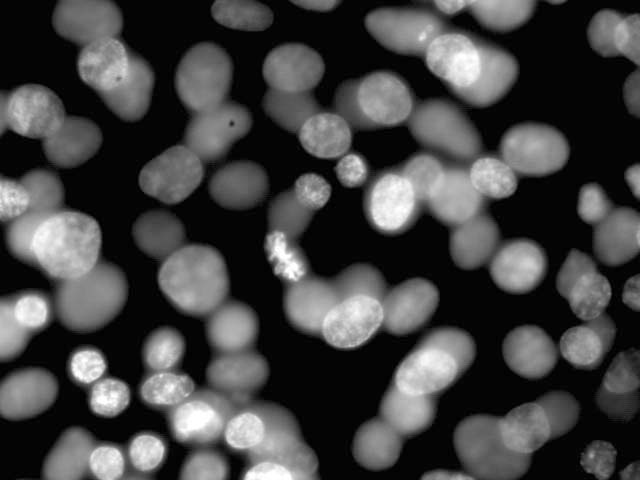

|
Structure and Function of Organisms
|
|
|
Dapi-L8 Cells |
||
|
Structure and Function of Organisms
|
|
|
Dapi-L8 Cells |
||
| Main Slides Page | Microscopy |
| Cheek Cells | Dapi Onion Root Tip |
| Diatoms | |
| Onion-aceto-orcein | Triple stained L8 cells |
| Tubulin | Vimentin |
 |
Dapi stain of L8 cells; a variety of stages are visible |
| Cell in anaphase |
 |
|
Cell in metaphase |
|
Cell in prophase |
 |
Biological Sciences | UT Lecture Hall
This site is maintained by the SBS
Webmaster
Last updated on
Wednesday December 05, 2001